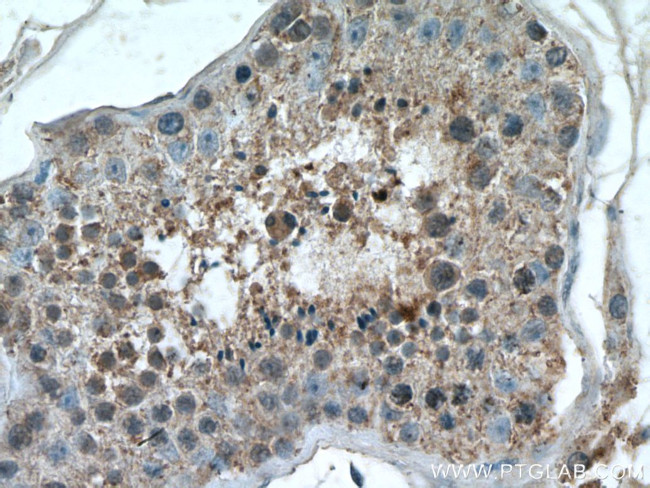
RHBDD1 Antibody in Immunohistochemistry (Paraffin) (IHC (P))

Search
Proteintech
RHBDD1 Polyclonal Antibody
{{$productOrderCtrl.translations['antibody.pdp.commerceCard.promotion.promotions']}}
{{$productOrderCtrl.translations['antibody.pdp.commerceCard.promotion.viewpromo']}}
{{$productOrderCtrl.translations['antibody.pdp.commerceCard.promotion.promocode']}}: {{promo.promoCode}} {{promo.promoTitle}} {{promo.promoDescription}}. {{$productOrderCtrl.translations['antibody.pdp.commerceCard.promotion.learnmore']}}
产品信息
20869-1-AP
种属反应
宿主/亚型
分类
类型
抗原
偶联物
形式
浓度
规格
纯化类型
保存液
内含物
保存条件
运输条件
产品详细信息
Immunogen sequence: SSSVGYPGR QYYFNSSGSS GYQDYYPHGR PDHYEEAPRN YDTYTAGLSE EEQLERALQA SLWDRGNTRN SPPPYGFHLS PEEMRRQRLH RFDSQ (13-106 aa encoded by B C027900)
靶标信息
The Rhomboid family of proteins is made up of several widely conserved polytopic membrane serine proteases that play roles in growth and development. RHBDD1 is highly expressed in the testis and is involved in the cleavage of BIK, a proapoptotic member of the Bcl-2 family. Overexpression or suppression by RNAi of RHBDD1 in 293 cells will reduce or enhance BIK-mediated apoptosis, respectively, demonstrating that RHBDD1 modulates BIK-mediated apoptotic activity. In GC-1 cells, a spermatogonia cell line that can differentiate into spermatids within the seminiferous tubules, suppression of RHBDD1 expression by RNAi caused the cells to lose the ability to survive and differentiate in mouse seminiferous tubules, suggesting that RHBDD1 may be associated with mammalian spermatogenesis.
仅用于科研。不用于诊断过程。未经明确授权不得转售。
生物信息学
蛋白别名: mRHBDD1; Rhomboid domain-containing protein 1; rhomboid like 4; Rhomboid-like protein 4; Rhomboid-related protein 4; rRHBDD1; RRP4; unnamed protein product
基因别名: 4930418P06Rik; HSD-50; HSD50; mRHBDD1; MSD-50; MSD50; RGD1306477; RHBDD1; RHBDL4; rRHBDD1; RRP4
UniProt ID: (Human) Q8TEB9, (Rat) Q4V8F3, (Mouse) Q8BHC7
Entrez Gene ID: (Human) 84236, (Rat) 316557, (Mouse) 76867